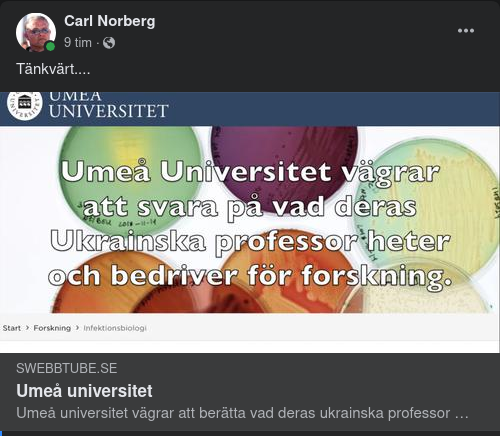
Umeå Universitet Tyst Om Ukrainsk Professors Forskning

Natomedlemsskapsblockerande Kroatien
2022-04-27
NATO-medlem säger att det kommer att blockera Sveriges, Finlands kandidatur "Vi ber inte Finland eller Sverige att byta namn till Ikea", sa den kroatiske presidenten Ur artikeln i RT ⬇️ Att Finland och Sverige går med i Nato är "mycket farligt charlataneri" och motsvarar att provocera Ryssland, sad